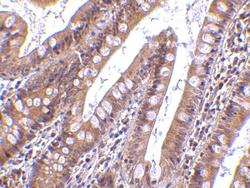

Antibody data
- Antibody Data
- Antigen structure
- References [0]
- Comments [0]
- Validations
- Western blot [1]
Submit
Validation data
Reference
Comment
Report error
- Product number
- A07404-1 - Provider product page

- Provider
- Boster Biological Technology
- Product name
- Anti-CIDE-B Antibody
- Antibody type
- Polyclonal
- Description
- Anti-CIDE-B Antibody validated for ELISA, WB, IHC, IF. Reactive to Human, Mouse, Rat.
- Reactivity
- Human, Mouse, Rat
- Host
- Rabbit
- Isotype
- IgG
- Vial size
- 0.1 mg
- Concentration
- batch dependent
- Storage
- At -20°C for one year. At 4°C for one month. It can also be aliquoted and stored frozen at -20°C for a longer time. Avoid repeated freezing and thawing.
No comments: Submit comment
Supportive validation
- Submitted by
- Boster Biological Technology (provider)
- Main image

- Experimental details
- Western blot analysis of CIDE-B in mouse small intestine tissue lysate with CIDE-B antibody at (A) 0.5
- Additional image